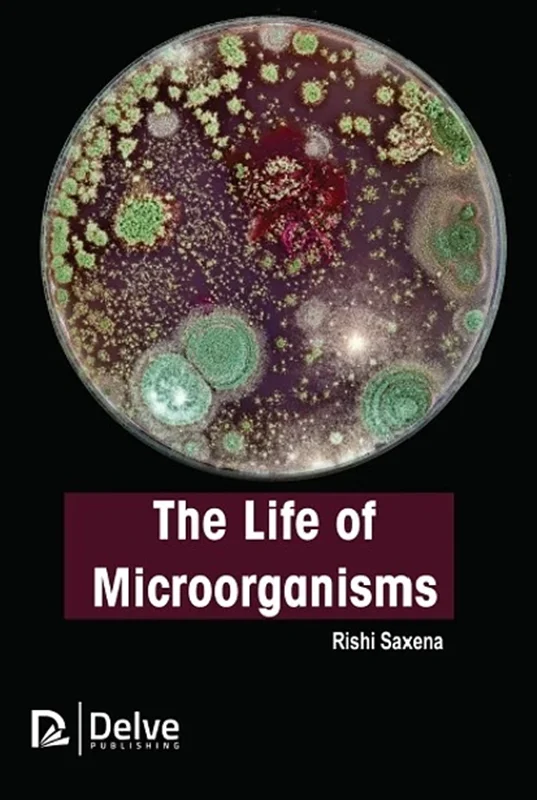
The life of Microorganisms

کارت اعتباری کتاب دانلود با 6,000,000 اعتبار دانلود کتاب! کلیک کنید
The life of Microorganisms
Rishi Saxena, 177469512X, 9781774695128, 978-1-77469-683-5, 9781774695128
English | 2023 | PDF | 20 MB | 251 Pages
This book explains the significance of microbes. It also gives a brief overview on microorganisms for sustainable environment and health. This book sheds light on the adaptation of microbial life to environmental extremes, factors affecting life and death of microorganisms, and recent advancements in microbial diversity.